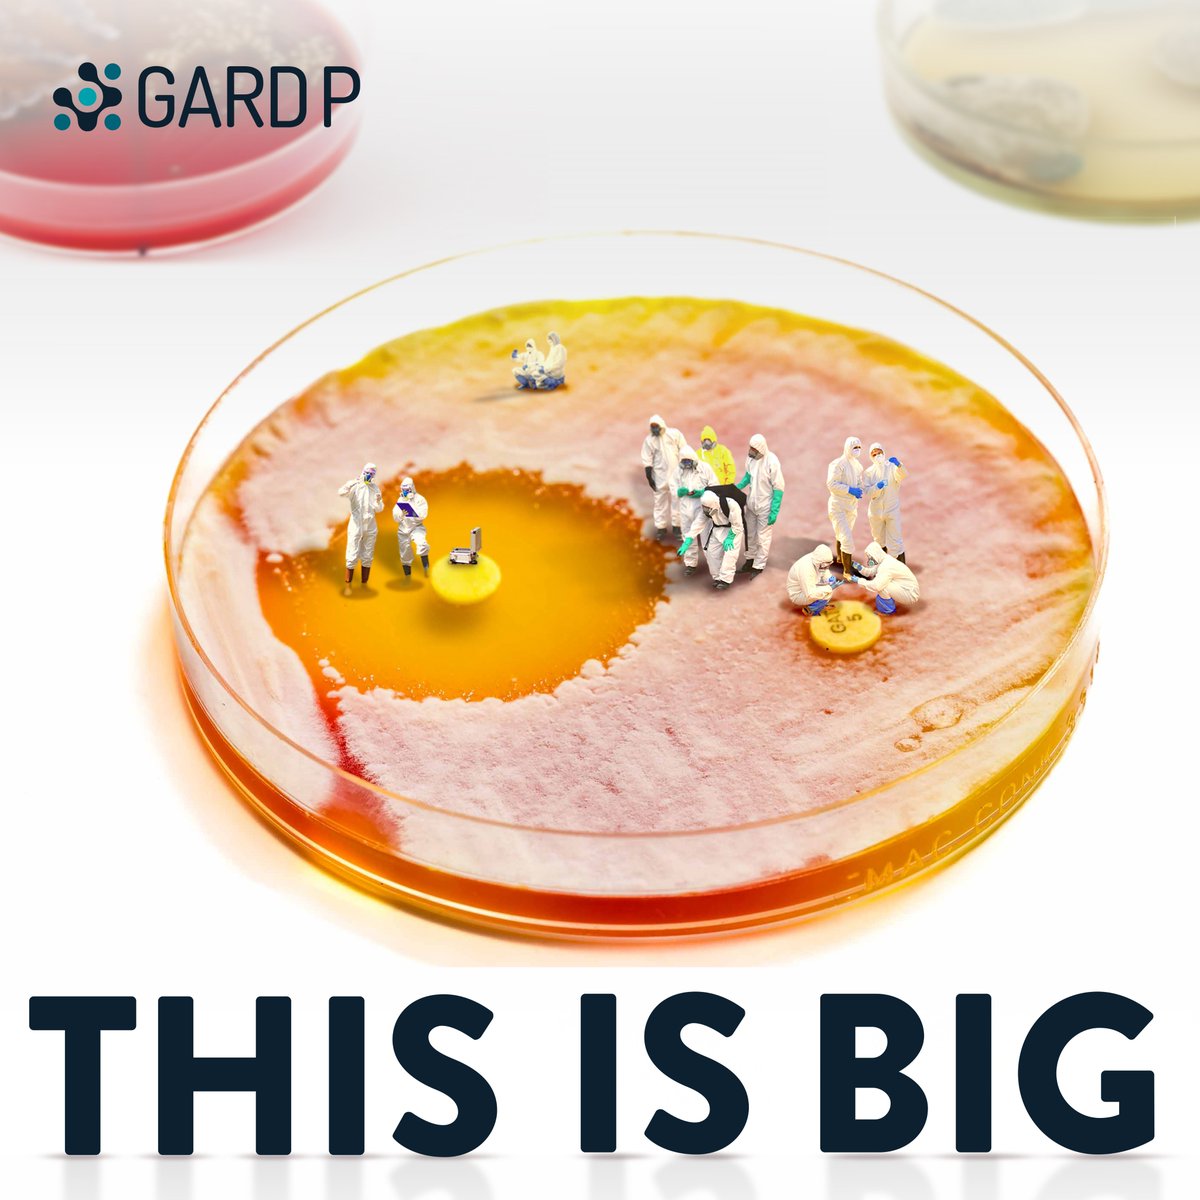
💥Drug resistance is rising, yet new antibiotics aren’t keeping pace – putting millions at risk.

GARDP is flipping the traditional R&amp;D model by prioritizing high-burden countries, targeting drug-resistant infections and ensuring access from day one.

THIS IS BIG:

Marie L G Attwood
@ree19872
Project manager / Head pK/pd scientist - abx/ biofilm/phage researcher - surveillance lead & GNA NOW Lead scientist/quality manager
ID: 1121894316501348353
26-04-2019 21:50:23
256 Tweet
337 Takipçi
2,2K Takip Edilen

Adding either FOF or TOB to C/T at simulated human clinically observed concentrations reduced P. aeruginosa bacterial loads & the risk of C/T resistance when strains had C/T MICs at or above the clinical breakpoint: doi.org/10.1093/jac/dk… Marie L G Attwood @OUPMedicine #JACNews






Our research Martha Clokie is available on ResearchGate: researchgate.net/publication/38…

Please look at the latest research produced by the pK/pD lab, Bristol ResearchGate: researchgate.net/publication/38…




Why BeckyMayerCentreforPhageResearch - alongside our phage colleagues globally, are doing the work we do articulated in 30 seconds!





Please check out the lasted work driven by Yojana Gadiya et al research . Available on ResearchGate: researchgate.net/publication/38…